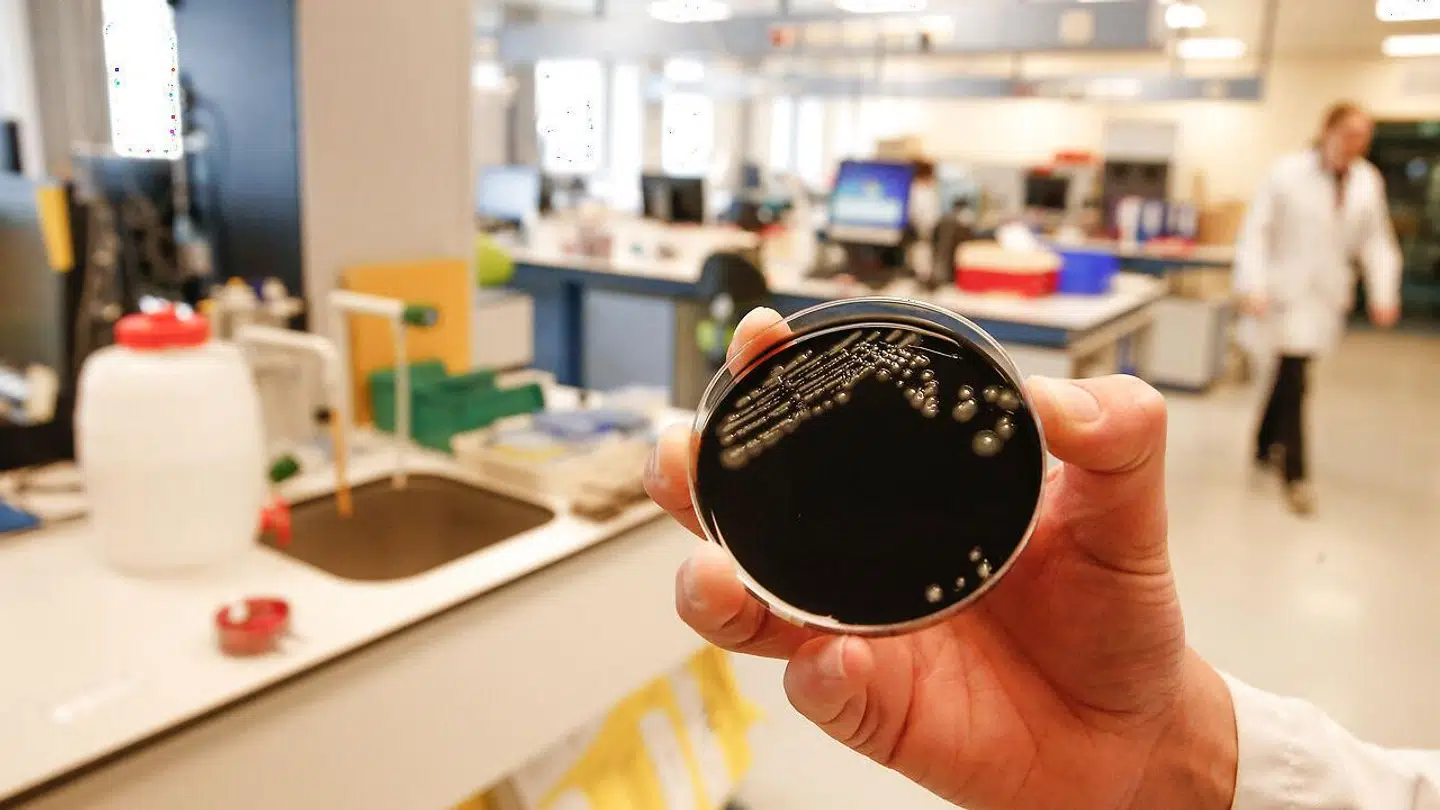
Der er fundet legionella-bakterier i det varme vand på et plejehjem i Højby. Her ses legionella-bakterier på et belgisk hospital (arkivfoto).

7. januar blev en beboer på Plejecenteret Solvognen i Højby vest for Nykøbing Sjælland indlagt med vejrtrækningsproblemer.
Plejehjemsbeboeren havde fået legionærsyge – og nu er der bekymrende nyt om, hvor vedkommende blev smittet.
Nykøbing Sjælland Svømmehal er netop nu lukket på grund af legionella-bakterier, så det kunne være nærliggende at tro, at plejehjemsbeboeren var blevet eksponeret for den farlige bakterie her.
Men det var ikke tilfældet, skriver TV2 Øst.
For beboeren havde ikke været i svømmehallen. Derfor blev der taget prøver fra det varme vand på Plejecenter Solvognen.
Nu er resultaterne klar – og de viser fund af legionella-bakterier i plejehjemmets vand.
Det skriver Odsherred Kommune i en pressemeddelelse.
Den smittede beboer blev indlagt på Holbæk Sygehus 7. januar, men blev udskrevet fire dage senere.
Odsherred Kommune oplyser, at beboeren »efter omstændighederne« har det godt, og at »de pårørende blev informeret«.
Der er ikke konstateret flere tilfælde af legionærsyge på plejehjemmet i Højby, men kommunen lover at holde vågent øje med, om andre beboere udvikler symptomer på den alvorlige sygdom.
Legionærsyge er ifølge Sundhed.dk en svær lungebetændelse med symptomerne høj feber, forvirring, hoste, åndenød og smerter i brystet. Nogle får også diarré og opkast tidligt i sygdomsforløbet.
Sygdommen kan behandles med antibiotika, men dødeligheden ligger ikke desto mindre på mellem fem og 15 procent. Langt de fleste smittede må indlægges på sygehuset og modtage behandling.
Legionella-bakterien – som forårsager legionærsyge – trives bedst i stillestående, lunkent vand, og smitte sker typisk ved indånding af forstøvet vand, eksempelvis under et brusebad.
Høj alder, KOL, rygning og nedsat immunforsvar på grund af andre sygdomme øger risikoen for smitte.